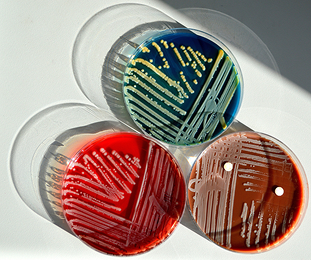
Bakterije

Znate li što je...?
Crijevna mikrobiota– skriveni svijet mikroorganizma
Jeste li znali da crijeva predstavljaju dinamičan ekosustav mikroorganizama koji sudjeluju u važnim tjelesnim funkcijama poput probave i metabolizma?
Mikrobiota i njezina uloga u ljudskom tijelu sve su češće predmet znanstvenih istraživanja. Neravnoteža u sastavu crijevnih bakterija područje je brojnih znanstvenih studija, posebno u području istraživanja probavnog sustava. Upravo zbog toga raste zanimanje za bakterijske kulture i dodatke prehrani koji ih sadrže, osobito u sklopu istraživanja o prehrani i mikrobiomu.
Što je mikrobiota?

Naše tijelo dom je trilijunima mikroorganizama – bakterijama, gljivicama i virusima – koji zajedno čine mikrobiom. Najveća i najraznolikija zajednica nalazi se upravo u crijevima, gdje oblikuje jedinstven ekosustav poznat kao crijevna mikrobiota. Iako je mikrobiom jedinstven poput otiska prsta, na njegov sastav mogu utjecati brojni čimbenici, uključujući prehranu, stres i korištenje antibiotika. Zbog toga raste interes za dodatke prehrani koji sadrže bakterijske kulture, osobito u kontekstu podrške zdravlju probavnog sustava. Znanstvena istraživanja sve više usmjeravaju pažnju na povezanost sastava crijevne mikrobiote i funkcioniranja ljudskog organizma.
Zašto je ravnoteža mikrobiote važna?

Ravnoteža crijevne mikrobiote ključna je za njezinu stabilnost i pravilno funkcioniranje. Kada dođe do njezina narušavanja – stanja poznatog kao disbioza – dolazi do promjena u sastavu mikroorganizama. Disbioza je sve češći predmet znanstvenih istraživanja, osobito u kontekstu probavnih smetnji i šireg utjecaja na cjelokupno zdravlje. Upravo zato raste interes za razumijevanje načina na koje čimbenici poput prehrane, stresa, lijekova i načina života utječu na ravnotežu mikrobiote.
Kako vratiti ravnotežu?

Održavanje ravnoteže crijevne mikrobiote može biti izazovno, osobito kada njezin prirodni sastav poremete čimbenici poput stresa, nepravilne prehrane ili primjene antibiotika i drugih lijekova, što se u stručnoj literaturi opisuje kao disbioza. Zbog toga sve više znanstvenih studija istražuje pojedinačne bakterijske sojeve i njihovu moguću primjenu u dodacima prehrani, s ciljem podrške ravnoteži mikrobiote i odvijanju prirodnih fizioloških procesa u našem organizmu.
Kako poremećena crijevna mikrobiota može utjecati na probavni sustav?
Nadutost
Osjećaj napuhnutosti i težine u trbuhu jedan je od najčešćih znakova neravnoteže u crijevnoj mikrobioti. Narušeni prirodni sastav bakterija u crijevima, može uzrokovat povećanu proizvodnju plinova i osjećaj nelagode.
Zatvor
Može se povezati s promjenama u crijevnoj mikrobioti koje utječu na normalnu funkciju probave. Neravnoteža crijevnih bakterija može usporiti pokretljivost crijeva, što može uzrokovati zatvor.
Proljev
Može nastati kada se naruši ravnoteža crijevne mikrobiote, primjerice nakon uzimanja antibiotika ili zbog nepravilne prehrane. Takve promjene mogu utjecati na apsorpciju vode u crijevima i dovesti do češćih i rjeđih stolica.
Upalne bolesti crijeva
Obuhvaćaju poremećaje koji uzrokuju upalu probavnog sustava. Iako točan uzrok nije u potpunosti razjašnjen, promjene u sastavu i crijevne mikrobiote smatraju se jednim od čimbenika koji mogu utjecati na njihov razvoj.
Sindrom iritabilnog crijeva
Stanje koje uključuje različite probavne smetnje poput bolova u trbuhu, nadutosti, proljeva ili zatvora. Istraživanja ukazuju na povezanost između promjena u sastavu crijevne mikrobiote i pojave simptoma.
Crijevna mikrobiota važan je čimbenik u pravilnom funkcioniranju probavnog sustava. Promjene u njezinu sastavu mogu utjecati na pojavu različitih probavnih smetnji, pa je važno razumjeti kako očuvati njezinu ravnotežu.
Prilikom odabira dodatka prehrani s mikroorganizmima, obratite pozornost na:
Bakterijske sojeve
Bakterijski sojevi imaju specifična svojstva, zbog čega je važno pažljivo birati dodatke prehrani s kulturama mikroorganizama. Preporučuje se odabir proizvoda s jasno navedenim sastavom, provjerenom kvalitetom i znanstveno dokumentiranom sigurnošću.
CDS22 sadrži 8 znanstveno istraženih sojeva koji imaju komplementarna svojstva.
Količinu bakterija
Visokokvalitetni dodaci prehrani s kulturama mikroorganizama sadrže velik broj bakterija i sojeve otporne na nepovoljne uvjete probavnog sustava. Ta otpornost pomaže im da ostanu vitalni tijekom prolaska kroz probavni sustav i dosegnu crijeva.
CDS22 sadrži 112 i 450 milijardi bakterija po dozi, ovisno o odabranoj formuli.

Znanstvenu podlogu
Preporučuje se odabir dodataka prehrani s kulturama mikroorganizama čija su svojstva ispitana u znanstvenim studijama i dokumentirana u stručnoj literaturi. Takve informacije omogućuju informiraniji i sigurniji odabir proizvoda.
CDS22–formula istražena je u preko 80 kliničkih studija.

Stabilnost
Na putu do crijeva, mikroorganizmi prolaze kroz kiselu sredinu želuca i djelovanje probavnih enzima. Zato je važno odabrati dodatak prehrani s otpornim sojevima bakterija koji mogu preživjeti ove uvjete i u dovoljnoj količini dospjeti do crijeva.
CDS22 sadrži sojeve otporne na izazovne uvjete probavnog sustava.

Certifikate i kvalitetu
Birajte dodatke prehrani s bakterijskim sojevima od provjerenih proizvođača, s jasno označenim sastavom i visokim standardima proizvodnje, kako biste bili sigurni u kvalitetu i sigurnost proizvoda.
CDS22 zadovoljava najstrože standarde kvalitete i priznata je od uglednih međunarodnih organizacija.

CDS22-formula proizvodi
Probavni sustav u ravnoteži – svakodnevni osjećaj ugode.
Imate pitanja ?
Zanima vas više o djelovanju CDS22–formule, načinu primjene ili dostupnosti u ljekarnama?
Tu smo da vam pomognemo.
Naš tim rado će odgovoriti na sva vaša pitanja – slobodno nam se javite!
Reference:
- Guandalini, S., et al. (2008). VSL#3 efficacy in pediatric IBS: international randomized crossover trial. American Journal of Gastroenterology, 103(9).
- Huynh, H. Q., et al. (2009). VSL#3 induces remission in pediatric acute UC: pilot study. Inflammatory Bowel Diseases, 15(5).
- Miele, E., et al. (2009). VSL#3 induction and maintenance of remission in pediatric UC. American Journal of Gastroenterology, 104(2).
- Sood, A., et al. (2009). VSL#3 induces remission in mild-to-moderate UC. Clinical Gastroenterology and Hepatology, 7(11).
- Jia, K., et al. (2018). Probiotics in inflammatory bowel disease: meta-analysis. Medicine, 97(51).
- Selinger, C. P., et al. (2013). VSL#3 prevents antibiotic-associated diarrhoea: randomized placebo trial. Journal of Hospital Infection, 84(2).
- Nguyen, N., et al. (2019). Treatment and prevention of pouchitis after IPAA in chronic UC. Cochrane Database of Systematic Reviews, 11(11).
- Kim, S.-E., et al. (2015). Fecal flora change and short-term VSL#3 in functional constipation. Journal of Neurogastroenterology and Motility, 21(1).
- Guandalini S et al 2008 Am J Gastroenterol 103(9)
- Huynh HQ et al 2009 Inflamm Bowel Dis 15(5)
- Miele E et al 2009 Am J Gastroenterol 104(2)
- Sood A et al 2009 Clin Gastroenterol Hepatol 7(11)
- Jia K et al 2018 Medicine 97(51)
- Selinger CP et al 2013 J Hosp Infect 84(2)
- Nguyen N et al 2019 Cochrane Database Syst Rev 11(11)
- Kim SE et al 2015 J Neurogastroenterol Motil 21(1)



